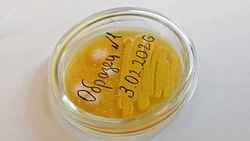
Медики предупредили жителей Чернянского округа об опасности ротавирусной инфекции

#профилактика
Лучшее за


Супруги Женя Джангоян и Аско Расоян из Чернянки стали участниками программы «Агростартап»
26 июня , 11:38


Владыка Иоанн наградил чернянских выпускников-медалистов
Вчера, 13:35


Российские власти ввели ряд льгот для участников СВО и членов их семей
23 июня , 14:15


Суд приговорил жительницу Чернянки к компенсации морального вреда за драку на свадьбе
25 июня , 16:32


Российские власти внесли изменения в порядок проведения экзаменов на водительские права
28 июня , 08:38
Все материалы
Последние новости
Все новости